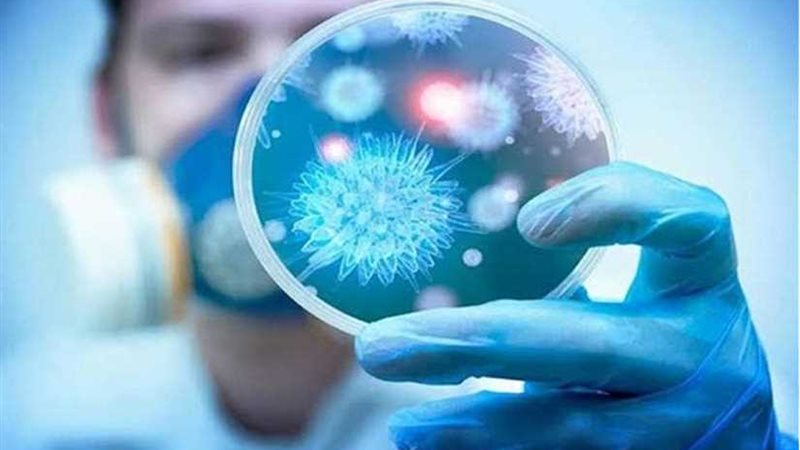
فرنسا تسجل ظهور 3

فرنسا تسجل ظهور 3 حالات إصابة بفيروس كورونا
أكدت فرنسا وقوع أول 3 حالات إصابة بفيروس كورونا الجديد في البلاد، مشيرة إلى وقوع حالتين في العاصمة باريس، وحالة إصابة ثالثة بمدينة "بوردو" جنوب غربي البلاد.
وذكرت قناة (فرانس 24) الإخبارية اليوم السبت أن جميع المصابين سافروا مؤخرا إلى الصين، مضيفة أنه تم عزل المصاب بفيروس كورونا في مدينة بوردو لتجنب حدوث أي تواصل بينه وبين العالم الخارجي وأن حالته تتحسن، وفقا لما ذكره مسؤولو الصحة في فرنسا.
من جهتها، أكدت الولايات المتحدة الأمريكية وقوع ثاني حالة إصابة بفيروس كورونا لسيدة سافرت إلى مدينة "ووهان" الصينية.
كانت الصين قد أعلنت تسجيل 41 حالة وفاة، و1297 إصابة مؤكدة بالالتهاب الرئوي الناجم عن فيروس كورونا الجديد في شتى أنحاء البلاد، بينها 237 إصابة في حالة حرجة.في حين وصل عدد الأشخاص المصابين حول العالم إلى أكثر من 1300 شخص .







